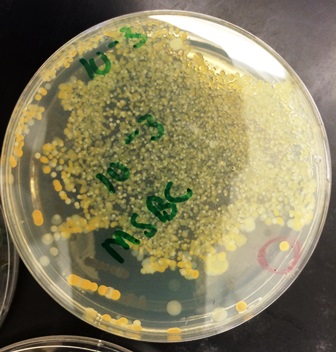
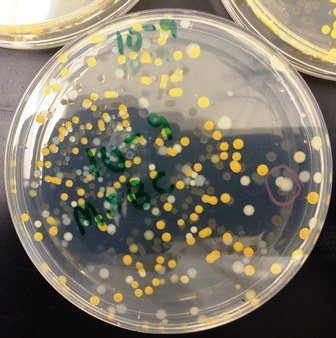
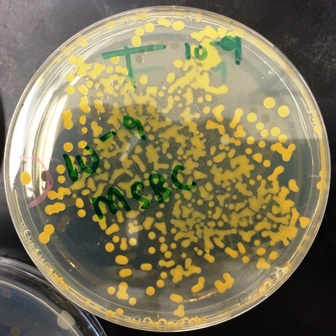

User:Megan Stocking/Notebook/Biology 210 at
07/07/2014 Biological Life on Campus: Observing A Mini Marsh, One of Many Niches at AU
Introduction
Biological life at American University is ecologically diverse. The biodiversity observed on campus is attributable to various types of ecosystems present throughout its entire physical landscape. Each ecosystem, or transect, is characterized by both its topographic and geographic features, as well as its biotic and abiotic components. The unique ecosystem surveyed for this lab belonged to transect #1, or the “mini marsh.” A marsh is a type of wetland, usually defined by terrestrially low-lying geographies, frequent incidence of flooding or presence of watershed, and grassy, herbaceous vegetation. The mini marsh is located on the Northeastern side of Main campus, on the lawn situated where busy Massachusetts Avenue perpendicularly meets the Kogod School of Business. The precise location of the transect is within closer proximity to the building entrance than the street, as it lies at the foot of the hill that proceeds outward from the building entrance, designating the beginning of the lawn of the lawn, or, at the innermost interior of the lawn with respect to the street on the other side. The transect area was not planar, but slightly sloped due to the area’s contiguity with more steeply sloping of parts of the surrounding landscape. To make a more informed hypothesis, some additional background information was gleaned from the American University Sustainability Homepage. Of the many initiatives set by AU to routinely accomplish “low-impact, low-maintenance, low-resource-use,” those of note included the use of native plants, preventing soil erosion with ground cover and dense planting on sloped areas, integrative pest management, and reducing harmful runoff (American University, 2014). Furthermore, "xeriscaping," a modern mechanism for manual landscaping that seeks to accomplish water-efficient vegetation by way of elemental design, has also been a proponent of AU across campus ecosystems. Based on this information, the following presumptions were made: 1)the initial construct of the marsh's design was made with respect to organism selection based on abiotic and biotic limitations, and 2) all of the expected ecological components would be present of an inland marsh. With those two things in mind it was hypothesized that a mutualist, efficient ecosystem would be observed of the mini marsh.
Materials and Methods
To begin the lab, access to the requisite transect was required; this was accomplished by going to the site of transect #1 on the Eastern side of Main campus. Adequate time was utilized to observe the biological life inhabiting transect #1, as well as the inorganic constituents contributing to the niche. A sterile 50mL conical tube was used to take a soil and ground vegetation sample representative of the ground surface of transect #1.
Results
Tables and Graphs
 Figure 2: Abiotic and Biotic Components
Figure 2: Abiotic and Biotic Components
Discussion
The initial hypothesis is supported based on the analysis of the components of transect #1 for numerous reasons. Not only were the abiotic and biotic components of the mini marsh consistent with the characteristics that typically define this type of niche, microbial analysis and secondary research also indicated that the transect was consistent with AU’s initiatives by way of ease of facilitation for the interrelation of abiotic and biotic components to carry out dynamic, mutualistic functions. Elemental design attributed to the efficiency of the marsh's ecosystem. The tall, white-flower-bearing plants were identified as the evergreen shrub Mountain Laurel (Kalmia latifolia), which is a native species that blooms in July, which explained the relative abundance of flower clusters present at that time. This species is perennial and requires only partial sunlight to sustain life. It also lives in wet, dry or clay soil sustained by the species’ deep lateral roots that render the species as drought-tolerable, and it can survive on any physical gradient. Summer blooming usually results in spring-like pollination assisted by bees (Virginia Department of Conservation & Recreation, 2014). This plant is also a vital component for butterfly wildlife, as butterflies feed on the nectar produced from the flowers. The nectar in these flowers is toxic for humans and most other large animals and this characteristic makes Mountain Laurels a safe haven for butterflies to lay eggs or undergo larvae development. This is just one of the many biotic components observed in the mini marsh, but its role is exemplary in terms of contributing to carrying out specific requirements for life within the niche.
Another family inhabiting the mini marsh is the fern plant. At least three species were identified, all native plants of the region: those identified were the Evergreen Wood fern (Dryopteris intermedia), the New York fern (Thelypteris noveboracensis), and the Holly fern (Cyrtomium falcatum). The fern plants varied between 1-3 feet in height and were represented on complementary quadrants equidistant from the sewage drain. This presence of fern species are akin to the Mountain Laurel as biotic components because both populations low-maintenance and ecologically efficient with respect to the conditions of their niche. Like the Mountain Laurel, ferns too are tolerable to shade and partial sunlight and their root systems make them extremely water-efficient. These ferns have rhizome roots, which grow into horizontal root systems that act not only in water and nutrient reserve, but also provide stability to the soil during harsher climates like winter. Ferns also provide ground coverage in the mini marsh niche (Jurries, 2013). Because of the way these fern species become rooted and grow, ferns are able to grow densely, on a multitude of gradients, and by doing so, the ferns can do two things: effectively block sunlight from being able to reach the ground beneath to facilitate the growth of weeds, and act as a barrier to rain drops from penetrating soil to the extent possible as the first line of defense to prevent soil erosion from rain water. Additionally, ground coverage provides a habitat for small animals like squirrels and birds. The ferns and the Mountain Laurel are both evergreen, which means that they lose their leaves gradually instead of all at once, indicating that this niche has a consistent source of organic compost.
The expected vegetation was present- abundant tall grasses, some herbaceous plan types, and there were also cattails. At first, the observation of cattails was concerning since they are known as an invasive species. However, given the proportion of common cattail (Typha latifolia) to those of the grass species present, it seemed that the cattail population was well within a controlled quantity. Three species of grass were identified and as native species, these were Deer Tongue grass (Dichanthelium clandestium), Little Bluestem grass (Schizachyrium scoparium), Longhair Sedge (Carex comosa). Deer Tongue grass tolerates high levels of aluminum in soil making it an ideal biotic component for filtration of storm water, and it sustains itself in acidic and infertile soils. Deer Tongue grass serves as a food source for insects including grasshoppers, caterpillars, and beetle species, as well as small mammalian herbivores such as rabbits. The seeds of Deer Tongue Grass are a food source for Sparrows (Virginia Department of Conservation and Recreation, 2013). Cattails and grasses act in concert to provide a water filtration system that maintains water quality, prevents polluted runoff that can impact the larger biosphere, and reduces the incidence of soil erosion caused by storm water or pollutant waste. Both plants absorb large amounts of phosphorous, a type of inorganic material that, if it were not filtered by the marsh vegetation, could be disposed through the sewage system and enter a local watershed where it may cause a toxic environmental condition called algal bloom (Jurries, 2003). Grasses bearing seeds are a food source for birds and small mammals, as well as the decayed grasses contribute to revegetation in the ecosystem’s biotic cycle. Cattails provide bird species with raw cotton product from which to make habitats. Lastly, it was observed, and subsequently understood through further investigation that microorganisms within the mini marsh niche play a tremendous role in its ecological success, contributing to the completion of biogeochemical and biotic cycling that involves both nonliving and living components as work (Carnegie Mellon, 2014). Plankton and algae that live in the soil of the marsh are two of many microorganisms that also play a particular role in the water filtration. Both protists types partially remove soluble forms of phosphorus and ammonia from storm water. Algae consumes nutrients and converts them into biomass which it remitted to the marsh’s soil for uptake by vegetation when needed in order to sustain growth and life (Jurries, 2003).
Because of fitness trade-offs and its subsequent effect on an organism’s tendency to adapt to a limited set of physical conditions, and because every organism has a specific range of tolerance for those conditions, or abiotic factors (Freeman, et al, 2014). When added that the ability of a species to persist in an area is limited by biotic factors, which relies on the living interrelationships within the niche, it is plausible to conclude that the mini marsh’s composition of native species is largely contributory to the efficiency and compatibility of the marsh’s ecosystem.
References
Freeman, Scott. Allison, Lizabeth. Quillin, Kim. 2014. “Biological Science.” Fifth Edition. Illinois: Pearson Education. Pages 169-185.
“Biogeochemical Systems.” 2014. Carnegie Mellon University Open Learning Institute. (Accessed July 6, 2014) <https://oli.cmu.edu/ >
Jurries, Dennis.January, 2003. "Biofilters (Bioswales, Vegetative Buffers, & Constructed Wetlands for Storm Water Drainage and Pollution Removal)." State of Oregon: Department of Environmental Quality. Accessed July 6, 2014. <http://www.deq.state.or.us/wq/stormwater/docs/nwr/biofilters.pdf>
Virginia National Heritage Program and Database Search. 2014. The Virginia Department of Conservation and Recreation. Accessed July 6, 2014. <http://www.dcr.virginia.gov/natural_heritage/dbsearchtool.shtml>
July 7, 2014 Microbial Ekaryotes: An Underappreciated and Vital Necessity
Introduction
All living things are made up of cells and a cell is classified by its internal structural complexity and by the way it obtains energy. Prokaryotic cells are unicellular, lack a true nucleus, and do not contain membrane-bound organelles. Eukaryotes may either be unicellular or multicellular, but do contain membrane bound nuclei as well as membrane-bound organelles. Living things are classified phylogenetically, based on common ancestral species and the descendant relationships that have resulted from evolution by natural selection. Prokaryotes are classified into either of two Domains- Domain Bacteria and Domain Archaea. Eukaryotes on the other hand, are classified into one of seven Domains. It was hypothesized that that the organisms inhabiting the niche at the top of the Hay Infusion Culture were likely going to be photosynthesizing organisms; therefore, it was highly probable that algae was going to inhabit the top niche, in order to access light to perform photosynthesis. The bottom niche was likely to be inhabited by aquatic microorganisms, such as plankton, and species acting as decomposers and consumers who are not carrying out photosynthesis.
Materials and Methods
A 50mL representative soil sample was collected from transect #1, American University's "mini marsh." A Hay Infusion Culture was made using a 11.6 grams of the soil sample, combined with 500mLs of water and 0.1 gram dried milk into a plastic jar. The contents were then mixed gently for 10 seconds. The lid was then removed and the open jar containing the mixture was stored in incubation for a period of two days inside of the laboratory. Following the incubation period, an entirely independent observable ecosystem was produced within the jar. Initial observations were made about the culture’s detailed appearance, smell, and speculative questions were noted. Four wet mounts were prepared from the culture. Two wet mounts contained samples taken from the top of the jar; the other two contained samples taken from the bottom of the jar. Of the two samples taken from the top of the culture, one slide contained a suspended sample collected from the surface of the liquid , and the other slide contained a sample from an attached growth adhered to jar wall. All four wet mounts were examined under compound microscopes until one organism had been successfully identified from each. A depiction for each organism was made, and measurements of the identified microorganisms were recorded.
Results
 Figure 1: Hay Infusion Culture, Transect #1
Figure 1: Hay Infusion Culture, Transect #1
The Hay Infusion Culture was murky with sedimentary particles at the bottom of the jar. The smell was odorous, like a strong mold akin to rotton food.
 Figure 2: Hay Infusion Culture, Top Niche
Figure 2: Hay Infusion Culture, Top Niche
The first two wet mounts were taken from this niche; the first was taken from the growth along the jar wall, and the second was taken from the liquid.
 Figure 3: Hay Infusion Culture, Bottom Niche
Figure 3: Hay Infusion Culture, Bottom Niche
The second two wet mounts were made from this niche, each sample was taken from a different area at the bottom of the jar.
 Figure 4
Figure 4
 Figure 5
Figure 5
 Figure 6
Figure 6
 Figure 7
Figure 7
Discussion
Two organisms were identified and observed that belonged to the niche present at the top of the Hay Infusion Culture; these organisms were Gonium and Pandorina. The Gonium colony observed consisted of approximately 8 cells. The second organism identified was Pandorina, a colonial form of green algae. Both organisms identified in the first [top] niche are very similar species; both are identified as members of the Chlorophyta group which are the green algae, and contain chlorophyll a and b unobscured by other accessory pigments like beta –carotene or other carotenoids (Bellinger, 2004). Pandorina is slightly more complex than Gonium, as both algae come from the volvocine series. Both Gonium and Pandorina were performing photosynthesis, acting as autotrophic producers in the ecosystem of the top layer niche of the Hay Infusion Culture. The primary differences between these two organisms were exhibited in their cytological presentations. The structural complexities that differentiate Pandorina from Gonium as a similar species were visible in the globular, motile colonial form observed of Pandorina, compared to that of the flattened, filamentous, branched colonial form of Gonium which was not observed to be motile at the time of study. The microorganisms identified from the bottom of the Hay Infusion Culture were both protists. The first microorganism identified was Arcella. By way of the dichotomous key, the microorganism was classified based on the observational determinants of colorlessness, motility exhibited by sliding slowly or floating without apparent motion, not possessing spherical shape, possessing a constant shape, and possessing a flattened test or shell without embedded or attached material in additional to exhibiting pale to brown color (Ward’s, 2002). Arcella is a zooplankton, the non-photosynthetic planktonic species, and relates to the Amoebozoa lineage. Arcella potentially serves as a bioindicator of the ecosystem in the Hay Infusion Culture, due to the species’ ability to survive in nutrient-depleted environments; it is also known as being an “oligotrophic bioindicator” for this reason (Hunt, 2001). Arcella species are heterotrophic decomposers and feed on detritus (Freeman, et al, 2014). The mechanism by which feeding is done Is phagocytosis, accomplished by Arcella’s flexible membrane that lacks cell walls and its finger-like projections , pseudopodia (Freeman, et al, 2014). The second microorganism identified from the bottom niche or the Hay Infusion Culture ecosystem was Stentor. The Stentor was classified according to the system, concluded by the observable characteristics of a ciliate possessing dark bluish-green color. Stentor is related to the ciliates and belongs to the Alveolata linkage. The Stentor was very motile and at least one of two present flagella was observed; cilia were visualized along the broader cellular end. The Stentor is a unique component to consider the biodiversity of the Hay Infusion culture compared with the other microorganisms because Stentor is a symbiont. In particular, Stentor and types of green algae have had symbiotic relationships, where Stentor consumes and gains nutrients from the algae, but the algae remains living and in turn sustains life using the Stentor’s metabolic waste (Methacton, 2013). Gonium is an example living organism that meets all five criteria for living organisms. It acquires and uses energy by way of respiration through photosynthesis. It is made up of cells, the fundamental units of life. Gonium contains DNA because it contains chloroplasts which contain DNA. Gonium replicates by isogamy, and its population within the algae continues to evolve, as Gonium is a descended species from a simpler unicellular organism, and other algae species, including Pandorina observed have proceeded as similar species. It appeared that the community within the Hay Infusion Culture was affected largely by the disturbance of nutrient availability, causing a disturbance in the metabolic balance of the organisms, and the respective biomass associated with the ecosystem's net productivity. It would be expected that in two months, the ecosystem would restore balance through use of the mechanisms that were observed in the identified organisms, including symbiotic relations, and continuance of biotic cycling.
References
"Protists." October 16, 2013: Methacton.org. (Accessed 7/6/14) <http://www.methacton.org/cms/lib/PA01000176/Centricity/Domain/345/protist%20book.pdf>
Freeman, Scott. Allison, Lizabeth. Quillin, Kim. 2014. “Biological Science.” Fifth Edition. Illinois: Pearson Education. Pages 2-500.
Hunt, Kendall. "Zooplankton." (2004) Kendall/Hunt Publishing Company: United States. Accessed 7/6/14. <http://books.google.com/books?id=FNyUfNu_PVMC&pg=PA223&lpg=PA223&dq=what+is+arcella+protist+in+ecosystem&source=bl&ots=G6_0tHOrOQ&sig=nqfHEL-a7Uk5EbYG5JuWnNF3BUM&hl=en&sa=X&ei=U925U4uhBpSuyASA8YLICg&ved=0CEsQ6AEwBQ#v=onepage&q&f=false>
July 9, 2014 Prokaryotic Bacteria: What Shapes, Stains and Antibiotics Indicate About Cell Structure
Introduction
Prokaryotes belong to the Domains Bacteria and Archaea. Prokaryotes are the phylogenetic desendants of the most primitive unicellular organisms. Prokaryotes do not contain membrane-bound nuclei, or membrane-bound organelles. Despite their simplistic morphology, prokaryotic cells do feature cell walls enclosing its cellular plasma membranes. Bacterial cell walls are made up on a complex polysaccharide made of amino acids called peptidoglycan. Peptidoglycan gives bacterial cell walls strength and firmness. Prokaryotic cells of organisms belonging to the Domain Archaea can be distinguished from bacterial cells because the compound peptidoglycan is exclusive to bacterial cell walls. The colonies analyzed in this lab were composed of prokaryotic bacterial cells, which meant that if cell walls were present, peptidoglycan compounds would be present. In order to further analyze the types of bacterial cells that grew on the agar plates, a gram stain was able to be introduced, a dyeing system used by biologists to distinguish two types of of cell walls. For gram-positive walls, a gram stain causes cells to look purple due to rentention of crystal violet dye, and for gram-negative, cells will look pink. Most cells with a positive gram stain feature a plasma membrane with extensive peptidoglycan (Freeman, et al, 2014). Cells with a negative gram stain usually have a plasma membrane enclosed by a gelatinous layer containing less peptidoglycan and an outer phospholipid bilayer (Freeman, et al, 2014). Nutrient agar is a growth medium used for culturing bacteria. Agar is composed of polymers which maintains a semi-solid consistency on which bacteria can grow because its composition acts as an inert gelling agent; added nutrients provide energy and nutrition for bacteria to grow. Because Archaea tend to grow in the most extreme natural environments, it was not expected that the agar plates in this lab would present with colonies consistent with Archaea species. However, it was hypothesized that bacterial growth representative of cells from species belonging Domain Bacteria would be present. Antibiotics are molecules that kill bacteria or stop them from growing; tetracycline is an antibiotic. Recent research has uncovered that antibiotic-resistance of bacterial strains are linked to the advantage that bacteria possess to grow as biofilms- dense colonial forms of bacteria enmeshed in a polysaccharide-rich matrix (Freeman, et al, 2014). Biofilms help shield bacteria from antibiotics. When antibiotics are administered to treat a bacterial growth or infection, they work by interrupting peptidoglycan synthesis; for example, in a gram-positive bacteria which contain extensive peptidoglycan, an administered penicillin attacks the existing cell wall and disrupts more peptidoglycan from synthesizing (Pearson, 2010). The peptidoglycan within gram-negative cells is much harder for antibiotics to penetrate, and therefore have much lower susceptibility to antibiotics; when antibiotics are administered to gram-negative bacterial cells, their cell walls are not completely destroyed (Freeman, et al, 2014). When added to an agar plate, antibiotics act as selective growth compounds on proliferating colonies of bacteria. Tetracycline is commonly found to be ineffective due to many resistant strains of bacteria. Therefore, it was hypothesized that the majority bacterial growth would be insensitive to tetracycline present.
Materials and Methods
A serial dilution was prepared using the Hay Infusion Culture from transect #1, American University's mini marsh. A series of eight corresponding agar plates were inoculated following the serial dilutions procedure; four petri dishes contained nutrient agar, and the other four contained nutrient agar with tetracycline. Immediately proceeding inoculation, the eight agar plates remained closed and were allowed to incubate for one week at room temperature. Following the incubation period, growth was observed on the agar plates inoculated from the Hay Infusion Culture. Qualitative data were recorded, and observations were made of the colonies formed. Three agar plates were then selected in order to isolate and analyze a single colony- these included two nutrient agar plates, and one nutrient agar with tetracycline. One colony from each plate was selected; traits were observed and recorded. A wet mount was made for each colony and observed under a microscope for cellular features. Oil immersion was utilized to view bacterial cells. A description of the cells viewed were recorded. Another sample was taken from each selected colony. With each sample, a gram stain was made according to the standard dying technique and sequential process. The completed stains were viewed at low magnification, observations were recorded and further analysis was applied to conclude cellular features based on the gram stain reaction.
Results
Figure 2: Nutrient Agar, 10^3 dilution, Colony A selected is circled in red (lower right quadrant)
Figure 2: Nutrient Agar, 10^3 dilution, Colony A selected is circled in red (lower right quadrant)
Figure 3: Nutrient Agar, 10^9 dilution, Colony B selected is circled in red (lower right quadrant)
Figure 3: Nutrient Agar, 10^9 dilution, Colony B selected is circled in red (lower right quadrant)
Figure 4: Nutrient Agar + Tetracycline, 10^9 dilution, Colony C selected is circled in red (middle left edge)
Figure 4: Nutrient Agar + Tetracycline, 10^9 dilution, Colony C selected is circled in red (middle left edge)
Based on the wet mounts, colonies B and C had similar cellular structures. Based on staining, colonies A and C had greater similarity in terms of cellular view, as well as both stains were gram positive while colony B stained negative. Colonies A and C had some physical characteristics in common to begin with, while colony be had the most numerous differing descriptive characteristics in terms of its colony description from the other two.
Tables and Graphs
Discussion
There were some observable differences when comparing the colonies formed on the nutrient agar plates with those on the nutrient agar and tetracycline. Based on colony count alone, in general, the agar plates were little if at all sensitive to the antibiotic; only one nutrient agar plate with tetracycline had less colonies than its nutrient agar-only counterpart, which was the 105 dilution. Even so, the tetracycline only reduced the colony count by half, not a majority. Also notable was the comparison between the 109 dilution plates. The nutrient agar plate presented with noticeably even margins compared to the tetracycline plate, but featured both yellow and white colonies. The formation of the tetracycline plate was entirely different in overall growth, exhibiting an irregular formation in lawn growth. At the molecular level, the wet mounts of the selected colony isolated from each plate presented with very similar structures; a dark, oblong structure was magnified from both, featuring an ornate series of vine-like characteristics. Interestingly, the gram stain did not provide the same similarity between the two plates. Instead, a the structure and staining visualized under magnification that belonged to the 109 tetracycline colony bore close similarity to the gram stain of the 103 nutrient agar colony; both colonies were of the same opaque yellow pigmentation, with even margins and bore closely related descriptive characteristics. Tetracycline’s mechanism of action is bacteriostatic. Tetracyclines accomplish this by way of protein synthesis inhibition by binding specifically to the 30S ribosome of a bacteria, which prevents the binding of aminoacyl-t-RNA- it is also important to note that this inhibition promoted by tetracycline is selective, and it is also reversible (Mayer, 2010). In this way, tetracycline stops the growth of bacteria, but does not kill it. It was once an effective treatment for numerous gram positive and gram negative strains of bacteria, however, its over use and reversible nature in mode of action has causes a significant amount of bacterial resistance to form against tetracycline, rendering it a much less effective antibiotic than it once was on a larger scale (Mayer, 2010). Because of the selective inhibition of tetracycline, its efficacy in is extremely variable in many bacteria for which it was once considered a “broad range” and first line antimicrobial treatment. Because of this variability, sensitivities to tetracycline may differ depending on the specific genetic mutability of the bacteria; in medical clinics, it is common for antibiotic sensitivity to be tested within a bacterial culture specimen. However, it has still been recorded that tetracycline effectively treats certain parasitic protozoans such as trichamonas (Mayer, 2010). The results were supportive of the hypothesis because, in large part, the bacteria was not sensitive to tetracycline. Further testing would need to be performed to evaluate the inoculations for similarities; for example, if a different colony for colony B had been selected that ad more traits in common with colony C, it may have been possible to draw preliminary conclusions about a particular colony with respect to antibiotic sensitivity. However, because the isolated colonies for B and C were fairly different regardless of their similar cell description, it was not possible to draw further conclusions.
References
Freeman, Scott. Allison, Lizabeth. Quillin, Kim. 2014. “Biological Science.” Fifth Edition. Illinois: Pearson Education. Pages 529-540.
Mayer, Gene. February 17, 2010. "Antibiotics: Protein Synthesis, Nucleic Acid Synthesis, and Metabolism." Microbiology and Immunology Online: The University of South Carolina School of Medicine. (Accessed July 9,2014). <http://pathmicro.med.sc.edu/mayer/antibiot.htm>
July 14, 2014 Land Plants in Biological Life at AU
Introduction
Green plants are comprised of two major types of organisms- the green algae and the land plants. The first green plants in the fossil record are green algae found in the rocks from 700-725 million years old (Freeman, et al, 2014). The first land plant fossils were found in rocks that were about 425 million years old. Biologists have determined that land plants evolved from green algae then diversified. In order to determine how green plants originated and diversified, biologists analyze morphological traits, the fossil record and phylogenetic trees estimated from similarities and differences in DNA sequences of plant species (Freeman, et al, 2014). This lab examined a series of five plant samples collected from transect #1, American University’s “mini marsh.” The plant samples were characterized in terms of three general features: vascularization, specialized structures, and reproduction. It was hypothesized that vascular tissue would be observed in the majority of transect plant samples. Vascular tissue is defined by specialized groups of cells that conduct water and nutrients from one part of the plant body to another (Freeman, et al, 2014). Other types of specialized features for carrying out life processes in plant life cycles includes the presence of cuticle, stomata, and guard cells. The evolution of cuticle allowed plant tissues to be exposed to air without dying, and the evolution of stomata, breaks in the cuticle consisting of pores controlled by guard cells, allowed plants to maximize gas exchange and minimize water loss (Freeman, et al, 2014). It was hypothesized that the flower and fruit bearing plants visible to the eye would be consistent with the features of angiosperms, including the characterization of seeds consisting of an embryo and a store of nutritive tissue, surrounded by a tough, protective layer indicating that all land-plants are embryophytes, meaning that eggs and embryos are retained on the parent plant (Freeman, et al, 2014).
Materials and Methods
Five land plant samples were collected from various locations within transect #1, American University's "mini marsh." The plant samples were brought back to the lab and analyzed for identification and analysis of general features, including vascularity, specialized parts and reproduction. Leaf anatomy was observed if present. Seeds and flowers, if present, were dissected to view internal parts and reproductive structures. Conclusions were made based upon the collective observations to identify the plant type and genera for each plant sample.
Results
 Figure 1: Little Bluestem grass (Schizachyrium scoparium)
Figure 1: Little Bluestem grass (Schizachyrium scoparium)
 Figure 2: Maleberry (Lyonia ligustrina)
Figure 2: Maleberry (Lyonia ligustrina)
 Figure 3:Mountain Laurel (Kalmia latifolia)
Figure 3:Mountain Laurel (Kalmia latifolia)
 Figure 4: Psilotophyta, whisk fern
Figure 4: Psilotophyta, whisk fern
 Figure 5: Pteridophyta, unidentified fern
Figure 5: Pteridophyta, unidentified fern
Figures 1, 2 and 3 are all angiosperm seed plants, while figures 4 and 5 are the samples that were collected identified as non-angiosperms. Figure 4 was a seedless vascular plant identified as a whisk fern, while figure 5 was also identified as a seedless vascular plant, and a fern but of a different type- Pteridophyta.
Tables and Graphs
Discussion
The tall grass sample was difficult to analyze for a number of reasons. A few characteristics were able to be deduced based on observations. It was deduced that the plant was vascular, evidenced by its upright stature and height of approximately 6 feet. Vascular tissue conducts water and has secondary cell walls reinforced with lignin that provides structural support allowing plants to grow upright, so that vascularity of this plant was able to be deduced much more readily than the other plants given its physical attributes (Freeman, et al 2014). Although the conical shape of the grass tip is morphologically similar to Equisetophyta, its consistency was more akin to a floral growth as opposed to sporangia. Additionally, the long, narrow leaves encircling the stem were inconsistent with Equisetophyta plants. Looking at the leaves, the veins are branching. A dissection of one of the seeds that stuck to one of the larger leaves surrounding the conical tip of the grass revealed a cotyledon consistent with an angiosperm classification as a dicot, with two cambers inside of the seed. Based on the alternation of generations, this plant consists of a multicellular sporophyte indicated by the conical region, which can make many spores and easily dispense them through wind currents. Since grasses are one the earliest ancestral species of angiosperms, it makes sense that their reproduction would possess characteristics of gametophyte-dominant life cycles. The second sample was also identified as an angiosperm through exhibition of many of the same properties observed from the tall grass. The white berry plant existed in the transect as a much shorter plant with much more branching amassed in shrub-type growth compared to the tall ad upright characterization of the grass. The white berry plant did not feature flowers, however, it did bear white spherical fruits and small brown seeds. A dissection of the white berries revealed white, sticky substance and a center cotyledon exhibiting dicot characteristics. The berry was consistent with depiction of seeds in seed-bearing angiosperms as entities consisting of an embryo and a store of nutritive tissue surrounded by a protective layer. The leaves of this plant featured what initially looked like parallel veins, but upon closer examination revealed a complex branching pattern of veins within the leaves which were also of shorter, wide, pear-like shape when compared to the long and narrow shape of the grass. This plant was vascular based on the stomata present on the leaves and necessity for it to uptake water via vascularization. Together, these properties were used to identify this plant as an angiosperm. The third sample was also identified as an angiosperm, inclusive of clusters of white-petaled flowers. The plant was tall and upright, featuring a height of 3-4” and narrow leaves encircling the stems. The clusters of white flowers were located at the tops of the plants. Upon dissection, several reproductive structures of the flowers were observed. A stamen was observed with inclusive parts- the anther and filament. The perianth was observed of one of the mature flowers. It was indicated that this plant reproduces via pollination by insects and other animals. This plant was identified as vascular, especially given the upright structure characterized by the cellular features of vascular tissue within the stems of the plant. The leaves were consistent with characteristic of the other two angiosperms, containing stomata and branches networks of veins. The size of the leaves was intermediate in length and width and was pear-shaped. The fourth sample was difficult to identify at first. Initially, it was presumed to be an angiosperm, bearing tiny pink flowers on the tips of its branches. However, secondary research and analysis of the observations better supports the identification of this plant as a whisk fern, a seedless vascular plant part of Psilotophyta. This plant was shrub-like and featured extensive branching in terms of growth, but its leaves were only located at the base of groups of branched regions. Whisk ferns characteristically feature branched stems with tiny outgrowths, which is consistent with the sample plant. The flowers were too small to dissect, but resembled tiny rosebuds. Reproduction is carried out asexually, by sporophyte-dominated life cycles, compared with ancestral gametophyte-dominated life-cycles. The transition is an evolutionary trait of land plants because sporophyte-dominated life cycles can better respond to varying environmental conditions. Mature spores are dispersed by wind and germinate into gametophytes that contain both achegonia and antheridia (Freeman, et al, 2014). The fifth plant sample was also identified as a fern, however, it was identified as Pteridophyta. The fifth sample did not contain flowers, nor did it bear fruits or seeds; thus, it was identified as a seedless plant. It was differentiated from the whisk fern because it featured well-developed leaves called fronds characteristically distinctive of Pteridophyta. This fern was vascular, albeit lacking true roots; however, it gains nutrition via underground stem networks called rhizomes which still makes it a vascular plant. The other plant samples have consisted of rhizomes as well. Fungi was not observed amongst any of the samples taken from the transect. However, sporangia are a common feature of fungi and some land plants as globelike structures that contain spores which bust upon maturity releasing those spores.
References
Freeman, Scott. Allison, Lizabeth. Quillin, Kim. 2014. “Biological Science.” Fifth Edition. Illinois: Pearson Education. Pages 523- 823.
July 16, 2014 Invertebrate Biology at AU
Introduction
Invertebrates represent a group of organisms that introduces the evolutionary development of animals. The radiation of animals began after the Cambrian explosion some 550 million years ago, but the theory of evolution holds that all organisms evolved from a common ancestor. The earliest animals to appear in the fossil record were the sponges, which belong to phylum Porifera. Sponges were very primitive and did not form tissues, however, biologists have determined that despite the morphological simplicity of sponges, sponges contained developmental "tool kits" of genes necessary for the basic molecular processes of animals (Freeman, et al, 2014). This tool kit included capabilities of specialization of cell types, regulation of cell cycling and growth, adhesion among cells, recognition, signaling and gene regulation, and programmed cell death (Freeman, et al, 2014). All other animal phyla do have tissue formation, likely contributed to the genetic innovation of multicellularity from primitive ancestors like the sponge. At the next basic animal phylogeny are the most primitive invertebrates, defined by embryonic tissues organized in layers called germ layers. Cnidaria and Ctenophora are amongst the most primitive invertebrates, which possess two germ layers, the ectoderm and endoderm. In animals with three germ layers, a mesoderm is also part of their body plan. In terms of evolutionary morphology, the ectoderm produces the covering of the animal including the skin and nervous system, the endoderm generates the digestive tract, and the mesoderm gives rise to the circulatory system, muscle, and internal structures (Freeman, et al, 2014).
Materials and Methods
A sample of leaf litter was collected from transect #1, American University's "mini marsh." The leaf little consisted of 90% dead or decaying plant matter and 10% soil; this was collected from the ground of the transect. A Berlese funnel was set up to collect invertebrates from the leaf litter sample. After one week, the ethanol solution attached to the Berlese funnel assembly was detached and the invertebrates were poured into petri dishes. The invertebrates were examined under a compound microscope, and four organisms were isolated and further examined. Observations were recorded.
Results
Tables and Graphs
Discussion
Of the invertebrates identified, each organism’s body plan consists of bilateral symmetry. Animals with bilateral symmetry have a central nervous system which is a variation from the most primitive sponge ancestors which neither had nerve cells or symmetry. The central nervous system is a “key innovation” that led to the diversification of bilaterians, or animals having bilateral symmetry and dates back to the radiative events of the Cambrian explosion (Freeman, et al, 2014). An important adaptation of the central nervous system to bilateral body plans was cephalization. Cephalization describes the evolution of an anterior head inclusive of structures and functions for basic sensory and information processing, opposed with the posterior portion of the body inclusive of other features for carrying out corresponding motor functions. All four organisms identified display these evolutionary traits. Organisms #1 and #4, the sucking lice and unidentified “mini-millipede” have a number of morphological similarities compared to the other two organisms. Both organisms featured visible segmentation within their body plan. Segmentation is defined by the presence of repeated body structures (Freeman, et al, 2014). Althought the other two organisms did not present with visible segmentation in the framework that the longitudinal shapes of the sucking lice and mini-millipede, anthropods also feature segmentation. Invertebrates are a paraphyletic group, and the segmentation within the flea and termite are different because of small changes in the expression of certain genes that resulted in immense diversification and lineages over time. The anatomy of organisms #2 and #3 exhibited limbs and appendages and more pronounced segments in terms of anterior and posterior body cavities. Biologists have concluded that all animal appendages have some form of genetic homology and were derived from appendages of a common ancestor that evolved during the early history of bilaterian organisms. It is thought that evolution by natural selection produced the diveristy of limbs seen today, and within the four identified organisms, there is evidence that the flea and termite are an evolved species that possess evolutionay traits in common with the sucking lice and mini-millipede. Not only did the sucking lice and mini-millipede feature longitude bodies comparatively, but both appear to be coelomates based on the shape of their body cavities. A coelom is a tube that encloses the mesoderm of bilaterian organisms which provides space for oxygen and nutrients to circulate, as well as provide efficient movement acting as a “hydrostatic skeleton” in soft-bodied animals (Freeman, et al, 2014). The coelom was also an evolutionary innovation. Organisms #2 and #3, the flea and termite, also likely possess coelom or are evolved from a coelomate ancestor because biologists have determined that animals identified as protostomes and deuterostomes based on their embryonic development. All four organisms are arthropods, and almost all animal species are protostomes (Freeman, et al, 2014). Protostomes are are defined by two developmental characteristics, one being the presence of a coelom formed later in the developmental life cycle, and the other being the development of an oral mouth before the anus (Freeman, et al, 2014). The termite was by far the most populous organism in the sample. Termites are part of a group of protostomes called Ecdysozoans. Ecdysozoans grow by shedding their external skeletons and expanding their bodies (Freeman, et al, 2014). Each of the three other organisms are also Ecdysozoans; the one organisms that varies is the mini-millipede which belongs to arthropod class myriapoda. The others belong to class insecta. In terms of processes, the mini-millipede, which was the largest organism identified, is a detritivore and feeds on dead plant material. The termite, flea, and sucking lice are more diverse. The sucking lice and termites are known as an ectoparasite, which feeds on its host and can affect humans and animals but also feed on algae and detritus. Fleas feed on other dead organisms, and live or dead plant tissues.
References
Freeman, Scott. Allison, Lizabeth. Quillin, Kim. 2014. “Biological Science.” Fifth Edition. Illinois: Pearson Education. Pages 640-1151.
July 28, 2014 Bacteria in Transect 1 by PCR Amplification
Introduction
Polymerase Chain Reaction, or PCR, is a method used to synthesize DNA from a known sample in order to obtain its sequence ,or a part of a sample's DNA sequence. During the gram-stain experiment, three types of bacteria were isolated and characterized by physical characteristics, wet prep microscopy, and gram-staining. The identity of the bacteria remained unknown and PCR provided a way to sequence the DNA of those samples in order to then gain a clear insight as to which precise bacterial species reside in transect 1. Although PCR was unsuccessful, a nucleotide sequence from a previous DNA sample of transect one was used to analyze the species that possess similar sequences of 16s ribosomal RNA.
Materials and Methods
PCR was set up to selectively amplify the 16s rRNA gene using the isolated bacteria from the Hay Infusion Culture of Transect 1. After the PCR product was made, it was incubated for one week in the biology lab. After the incubation period, a gel electrophoresis was run on the PCR product. The DNA was then sent out for sequencing. A nucleotide sequence of unknown DNA was input to NCBI blast from a previous year’s study of Transect 1. The following DNA sequence was used for the data and discussion of this lab:
>S1-T1-12 TCAGCTACTCTCACGAGAGTAGGTTTATCCCTATACAAAAGAAGTTTACAACCCATAGGGCCGTCGTCCTTCACGCGGGA TGGCTGGATCAGGCTCTCACCCATTGTCCAATATTCCTCACTGCTGCCTCCCGTAGGAGTCTGGTCCGTGTCTCAGTACC AGTGTGGGGGATCACCCTCTCAGGCCCCCTAAAGATCGTAGACTTGGTGAGCCGTTACCTCACCAACTATCTAATCTTGC GCGTGCCCATCTCTATCCACCGGAGTTTTCAATATCAAGTGATGCCACTTAATATATTATGGGGTATTAATCTCCCTTTC GAAAGGCTATCCCCCAGATAAAGGCAGGTTGCACACGTGTTNCGCACCCGTACGCCGCTCTCTCATTTCCGAAGAAACAA TACCGCTCG
Tables and Graphs
Table 1: Bacteria Characteristics

Discussion
The nucleotide sequence matched several strains of Chryseobacteria, with the first match being species StRB028. Chryseobacteria is a gram-negative bacteria, which in many strains has been identified as rod-shaped and golden yellow in color. Chryseobacteria can be isolated from a multitude of sources, from freshwater to soil, surfaces of root potatoes, rhizomes and of organisms such as fish. Chryseobacteria is described as indole because of its odorous smell and association with decomposition byproducts when present- including in conjunction with contamination from fecal matter, fermentation, and surface bacteria on organisms associated with disease. The second type of bacteria identified by the sequence was Flavobacterium. Like Chryseobacterium, Flavobacterium is gram-negative and usually rod-shaped. Various strains produce colors ranging from red and brown to orange and yellow, but the vast majority of colonies are found with a golden yellow, round, shiny appearance. Flavobacterium exists in a multitude of habitats and varies concerning the type of water present- this includes freshwater, saltwater and other types of aquamarine environments, and it is found in similar places to Chryseobacterium, including in soil, organic matter, and on the surface of animals. Flavobacterium has been known to exert varying degrees of pathogenicity depending on the strain and some are extremely antibiotic resistant. Both of these types of bacteria would seem appropriate given the characters of the isolates examined, including the physical descriptions of both as yellow and rod-shaped, as well as their respective biological requirements and compatibility with the ecology of transect 1. The known isolates were also yellow and odorous, as well as displayed properties of antibiotic resistance; it would make sense that these two isolates would be found in transect 1. There were a number of limitations with this experiment, beginning with the inability to sequence the DNA from transect 1 derived from the Hay Infusion Culture in order to compare and contrast the bacteria analyzed with its true sequence. The nucleotide sequence used from a previous sample of transect 1 was still helpful and indicative of likely identities of the bacteria that was analyzed during the gram-stain experiment, but it is still not conclusive. The nucleotide sequence may have been taken from another season of the transect, which could have presented in culture with vastly different properties as well; this is another limitation that was faced.
References
"Genus Chryseobacterium." LPSN. Accessed July 28, 2014. Available at http://www.bacterio.net/chryseobacterium.html.
"Flavobacterium sp. PH1 16S ribosomal RNA gene, partial sequence." NCBI Nucleotide Blast. Accessed July 27, 2014. Available at http://www.ncbi.nlm.nih.gov/nucleotide/171474491?report=genbank&log$=nucltop&blast_rank=4&RID=X8YM636J014.
"Chryseobacterium sp. StRB028 gene for 16S rRNA, partial sequence." NCBI Nucleotide Blast. Accessed July 27, 2014. Available at http://www.ncbi.nlm.nih.gov/nucleotide/304555522?report=genbank&log$=nucltop&blast_rank=1&RID=X8YM636J014.
Korin, Michael. "Flavobacterium." Soil Microbiology. Accessed July 28, 2014. Available at http://www.filebox.vt.edu.













